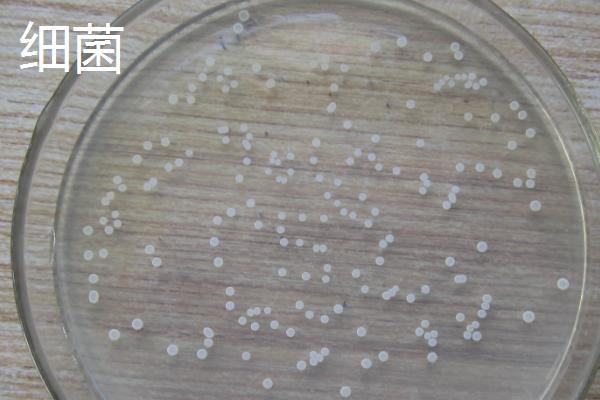
菌菇与细菌的区别

物种不同:菌菇是指可以形成大型肉质或胶质子实体,并能供人们食用的大型真菌,细菌是指生物的主要类群之一,它们是疾病的病原体。
体型不同:菌菇肉眼可见,比如香菇的菌盖直径为5-12厘米左右,细菌只能借助显微镜才能看到。
构造不同:菌菇由菌丝、孢子、菌盖、菌褶、菌柄组成,细菌结构简单,多为单细胞。
一、物种不同
1、菌菇:是指可食用的真菌,即能形成大型肉质或胶质子实体(或菌核类组织),并能供人们食用(或药用)的一类大型真菌。
2、细菌:是指生物的主要类群之一,它们是许多疾病的病原体,可通过各种方式进行传播。

二、体型不同
1、菌菇:肉眼可见,大小、形态因品种而异,常见的香菇其菌盖直径为5-12厘米左右。
2、细菌:个体极小,无法直接用肉眼看见,只能借助显微镜观察。
三、构造不同
1、菌菇:由菌丝、孢子、菌盖、菌褶、菌柄组成,外观和雨伞有些相似。
2、细菌:多为单细胞,结构简单,缺乏细胞核、细胞骨架、膜状胞器。

四、作用不同
1、菌菇:一般可食用,部分品种可以入药。
2、细菌:分为有害菌和有益菌,有害菌会传播疾病,危害人体,有益菌可用来酿酒、制作抗生素,还能用来处理废水。
三农问答